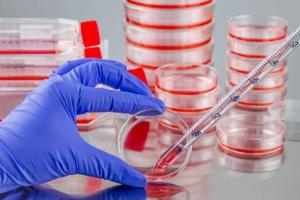

Cell Culture Market Present Scenario, Advanced Techniques, Applications, and Growth Opportunities| VWR International LLC
Cell Culture market is estimated to be valued at US$ 19,198.0 million in 2022 and is expected to exhibit a CAGR of 7.2% during the forecast period (2022-2030).
BURLINGAME, CALIFORNIA , UNITED STATES, November 3, 2023 /EINPresswire.com/ -- The Cell Culture Market is a significant segment within the life sciences and biotechnology industry, focusing on the production and distribution of in vitro cell culture systems and related products. These systems are essential for growing and studying cells outside of living organisms, serving critical roles in various fields, including drug development, biopharmaceutical manufacturing, and basic cell biology research. The market encompasses a broad range of cell culture products such as media, reagents, cell lines, and equipment, catering to research institutions, pharmaceutical companies, and biotechnology firms that rely on these tools to advance scientific discoveries, develop therapies, and produce biologics for medical and industrial applications.The research study conducted by Coherent Market Insights on the "Cell Culture Market" spans over 100 pages and delves into various facets of this market. It analyzes the business strategies adopted by emerging industry players, examines the geographical scope, dissects market segments, evaluates the product landscape, and investigates price and cost structures. This research report facilitates market segmentation based on the latest Market trends, geographical market, and technological advancements. Each section of the report is meticulously prepared to scrutinize key aspects of the market. Moreover, it includes a detailed analysis of current applications, comparing them while focusing on opportunities, threats, and conducting a competitive analysis of major companies.
The report offers a comprehensive understanding of market segments created by combining different factors such as types, applications, and regions. Furthermore, it discusses key drivers, restraints, potential growth opportunities, and market challenges.
Get an Exclusive Sample Copy of the Report at: - https://www.coherentmarketinsights.com/insight/request-sample/116
Scope of the Cell Culture Market:
The Global Cell Culture market is expected to witness significant growth between 2023 and 2030. In 2022, the market is already growing steadily, and with the increasing adoption of strategies by key players, it is projected to experience substantial growth in the coming years.
The report covers extensive competitive intelligence which includes the following data points:
Business Overview
Business Model
Financial Data
Financial – Existing
Financial – Funding
Product/Service Segment Analysis and specification
Recent Development and Company Strategy Analysis
SWOT Analysis
Competitor Analysis:
Key players in the global Cell Culture market include:
◘ Corning Incorporated
◘ Merck KGaA
◘ Sartorius AG
◘ BioSpherix Ltd.
◘ Cell Culture Company LLC
◘ Thermo Fisher Scientific Inc.
◘ VWR International LLC
◘ Lonza.
The information for each competitor includes:
Company Profiles
Company Overview
Product Portfolio
Financial Performance
Recent Developments/Updates
Strategies
Market Segmentation:
This report explores key segments by type and application. Industry experts have examined the potential for profitability and growth within these segments. The report also provides revenue forecasts based on value for the period 2023-2030.
By Product Type:
Instrument
Culture Systems
Vaccines
Bags
Plates
T-flasks
Culture Dishes
Roller Bottles
Bioreactors
Incubators
Pipetting Instruments
Roller Bottle Equipment
Biosafety Cabinets
Cryostorage Equipment
Others
Consumables
Media
Chemically Defined
Classical
LB
Protein-free
Serum-free
Specialty
Sera
Fetal Bovine
Others
Reagents
Albumin
Amino Acids
Attachment Factors
Growth Factors
Protease Inhibitors
Thrombin
Others
By Application:
Vaccine Production
Gene Therapy
Cancer Research
Tissue Culture
Drug Development
Others
By End User:
Academic & Research Institutions
Pharmaceutical and Biotechnology Companies
We Offer Customized Report, Click @ https://www.coherentmarketinsights.com/insight/request-customization/116
Regional Analysis of Cell Culture Market:
North America (United States, Canada, and Mexico)
Europe (Germany, France, UK, Russia, and Italy)
Asia-Pacific (China, Japan, Korea, India, and Southeast Asia)
South America (Brazil, Argentina, Colombia, etc.)
The Middle East and Africa (Saudi Arabia, UAE, Egypt, Nigeria, and South Africa)
Impact of Covid-19:
Covid-19 had a significant impact on nearly all industries, but the technology sector saw increased revenue due to changes in consumer preferences towards technological services. The pandemic has also accelerated technology adoption in both developing and developed countries.
Key Benefits for Stakeholders:
The report offers a quantitative analysis of current trends, estimates, and market dynamics from 2023 to 2030, aiding stakeholders in identifying the most promising opportunities.
Porter’s five forces analysis highlights the significance of buyers and suppliers in helping stakeholders make profitable business decisions and expand their supplier-buyer network.
In-depth analysis, market size, and segmentation assist in recognizing current opportunities in the Cell Culture Market.
The report maps the largest countries in each region based on their revenue contribution to the market.
The report provides a comprehensive analysis of the current status of major players in the Cell Culture Market.
Buy This Premium Report and Get Upto 25 % OFF: https://www.coherentmarketinsights.com/insight/buy-now/116
Reasons to Purchase the Cell Culture Market Report:
Gain insights into both current and future prospects for the Cell Culture Market in developed and emerging markets.
Utilize Porter’s five forces analysis to understand various aspects of the market.
Identify the regions expected to experience the most rapid growth during the forecast period.
Stay updated on the latest advancements, market shares, and strategies of top market players.
Frequently Asked Questions:
What is the primary driver for the growth of the global Cell Culture market?
What factors are restraining the market?
Who are the key players in the market?
Which region holds the largest market share?
What are the recent trends in the global Cell Culture market?
Why Us:
We offer exceptional after-sales support.
Our reports provide comprehensive insights into the Cell Culture market.
We offer a one-stop solution for all Cell Culture market-related information.
We can provide customized reports to meet client needs.
About Coherent Market Insights
Coherent Market Insights is a global market intelligence and consulting organization that provides syndicated research reports, customized research reports, and consulting services. We are known for our actionable insights and authentic reports in various domains including aerospace and defense, agriculture, food and beverages, automotive, chemicals and materials, and virtually all domains and an exhaustive list of sub-domains under the sun. We create value for clients through our highly reliable and accurate reports. We are also committed in playing a leading role in offering insights in various sectors post-COVID-19 and continue to deliver measurable, sustainable results for our clients.
Mr. Shah
Coherent Market Insights Pvt. Ltd.
+1 206-701-6702
email us here
Visit us on social media:
Facebook
Twitter
LinkedIn
Legal Disclaimer:
EIN Presswire provides this news content "as is" without warranty of any kind. We do not accept any responsibility or liability for the accuracy, content, images, videos, licenses, completeness, legality, or reliability of the information contained in this article. If you have any complaints or copyright issues related to this article, kindly contact the author above.